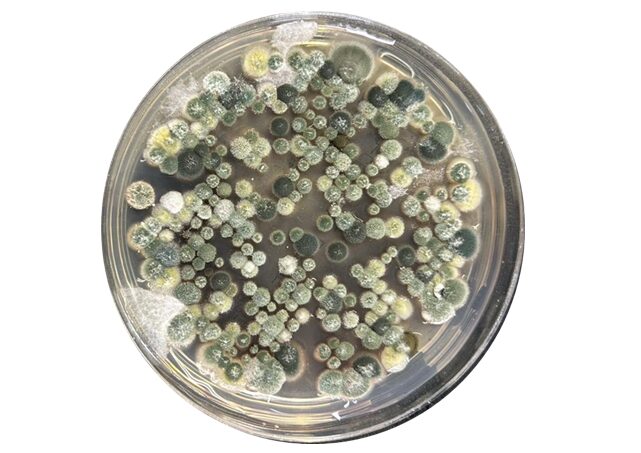

学校の寮でカビが発生し、室内環境についてご相談をいただいたため、ハーツリッチ株式会社(ハーツクリーン事業部)が現地調査を実施しました。
寮は日常的に人が生活する空間のため、見た目だけで判断せず、汚染の広がりと背景要因を整理する視点が重要です。
今回は目視確認に加え、浮遊菌検査・付着菌検査・含水率測定を行い、室内環境の状態を多角的に確認しました。
1. 今回の調査で行ったこと

今回の調査では、現状把握のために複数の検査を組み合わせて実施しました。
1-1. 空気中のカビを確認する浮遊菌検査
室内環境の状態を数値で把握するために、空気中に浮遊するカビを採取し、その結果をCFU/100L(100Lあたりのコロニー形成単位)で数値化しました。
浮遊菌汚染度の目安は次の通りです。
| 区分 | 判定基準(CFU/100L) |
|---|---|
| 清潔区域 | 5 以下 |
| 準清潔区域 | 20 以下 |
| 準汚染区域 | 21〜99 |
| 汚染区域 | 100 以上 |
あわせて、採取試料を培養し、主なカビ属を簡易同定しました。
1-2. 家具まわりの付着菌検査
ベッドのスノコ裏面を中心に、表面に付着している菌量を測定しました。
見えにくい裏面に菌が定着していないかも確認しています。
付着菌汚染度の目安は次の通りです。
| 菌数(CFU/100cm²) | 判定 |
|---|---|
| 1〜500 | 清潔 |
| 501〜3,000 | 注意 |
| 3,001以上 | 汚染 |
1-3. 壁・天井・家具の含水率測定
カビの増殖には水分が大きく関係するため、壁や天井などの建材に加え、家具などの木部についても含水率を測定しました。
木材は含水率が20%を超えるとカビが発生しやすくなるため、木部の数値は特に注意して確認しています。
これにより、湿気の影響が建物側にあるのか、家具側にあるのかを見極める材料としています。
2. 浮遊菌検査の結果|1階の一部居室で高い数値を確認
複数箇所で空気中のカビ量を測定した結果、1階の一部居室で100 CFU/100L以上(汚染区域)に該当する数値が確認されました。
| 測定箇所 | 浮遊カビ数 | 評価 |
|---|---|---|
| 1階居室A | 214 | 汚染 |
| 1階居室B | 144 | 汚染 |
| 1階居室C | 34 | 準汚染 |
| 1階居室D | 19 | 準清潔 |
| 1階共用部A | 33 | 準汚染 |
| 1階共用部B | 8 | 準清潔 |
| 2階共用部 | 17 | 準清潔 |
| 3階共用部 | 1 | 清潔 |
今回の結果では、施設全体が一律に高いというより、1階エリアの一部居室に汚染が集中している傾向が見られました。
一方で、2階・3階は比較的良好な状態で、汚染が建物全体に均一に広がっている状況ではないことも確認できました。
3. 付着菌検査の結果|家具裏面で高い汚染が確認
1階の4居室のベッドのスノコ裏面を対象に付着菌を測定したところ、全箇所で「汚染」に相当する結果が確認されました。
| 測定箇所 | 総菌数 | 評価 |
|---|---|---|
| 居室A ベッド スノコ裏 | 15,530 | 汚染 |
| 居室B ベッド スノコ裏 | 12,080 | 汚染 |
| 居室C ベッド スノコ裏 | 9,640 | 汚染 |
| 居室D ベッド スノコ裏 | 5,890 | 汚染 |
付着菌は3,001以上が「汚染」の目安とされており、今回の数値はいずれもその基準を大きく上回っていました。
付着菌検査は、空気中の菌数だけでは把握しにくい汚染源の有無を確認するのに有効です。
今回の結果から、空気環境に加え、家具などの表面にも汚染が残っている可能性が示唆されました。
4. 検出された主なカビの種類
培養結果をもとに、空気中に存在していた主なカビを整理すると、以下が確認されました。
- アスペルギルス属
- ペニシリウム属
- クラドスポリウム属
- アルタナリア属
- クモノスカビ
今回確認されたカビには、乾燥に比較的強く、胞子が飛散しやすい種類が含まれていました。
そのため、表面だけを乾拭きするような対応では、胞子を室内に広げてしまう可能性があるため注意が必要です。
5. 含水率測定の結果|壁・天井は低水準、木部の一部は高含水率
含水率を確認したところ、壁や天井は低水準だった一方で、家具木部では高い数値を示す箇所がありました。
| 測定対象 | 含水率 |
|---|---|
| 壁 | 0.8〜1.5% |
| 天井 | 0.4〜0.5% |
| 共用部の壁 | 1.1〜1.2% |
| 木部(家具) | 10.3〜27.9% |
木材は含水率20%を超えるとカビが発生しやすいと言われていることから、今回の結果では建物の壁面よりも家具側にリスクが偏っている可能性がうかがえました。
6. 調査結果から考えられる発生要因
今回の調査結果から、カビ発生の背景として、主に次のような要因が考えられます。
6-1. 1階エリア特有の環境条件
浮遊菌検査では、高い数値は主に1階で確認されました。
一般的に1階は立地条件や日照の影響を受けやすく、湿気がこもりやすい傾向があります。
こうした環境条件が重なり、1階で汚染が進みやすかった可能性が考えられます。
6-2. 季節的な高温多湿
春から秋にかけては気温・湿度が上がりやすく、室内がカビの成長に適した状態になりやすくなります。
また、暖房の使い方によっては、冬場でも結露や湿気の滞留が起こることがあります。
こうした季節要因と運用条件が重なることで、発生リスクが高まった可能性が考えられます。
6-3. 家具木部の高含水率

含水率測定では、壁・天井よりも家具木部で高い数値が確認されました。
このことから、建物側よりも家具側に水分が残りやすい状態があったと考えられます。
その結果、家具まわりが汚染源となっていた可能性も示唆されます。
6-4. 清掃・初期対応による胞子拡散の可能性
今回検出されたカビには、乾燥に比較的強く、胞子が飛散しやすい種類が含まれていました。
そのため、初期段階での清掃方法によって、胞子が周囲に拡散した可能性があります。
7. 調査結果を踏まえた対応方針

今回の調査結果を踏まえ、現場で想定されるリスクと優先順位を整理したうえで、次の対応方針をご提案しました。
7-1. 汚染度が高い居室の優先対応
数値が高かった1階の一部居室は、優先して除カビ・防カビ対応を進める必要があります。
空気中の菌数が高い箇所は、汚染源の除去と再発防止をセットで進めることが重要です。
数値が高かった居室を優先しつつ、1階全体を視野に段階的に進める方法が適しています。
7-2. 家具木部・スノコ裏面の重点処置
今回の調査では、壁・天井は低含水率だった一方、スノコ裏面では高い付着菌数、家具木部の一部では高い含水率が確認されました。
そのため、表面的な清掃にとどめず、家具側を重点的に処置することが改善のポイントになります。
再発を防ぐためには、裏面など見えない部位まで含めた対応が欠かせません。
7-3. 換気・湿度管理の見直し
今回の結果では、1階を中心に汚染が確認されており、湿気がこもりやすい環境条件が重なっていた可能性があります。
そのため、換気や空気循環の運用を見直し、湿気が滞留しにくい状態を維持することが重要です。
湿度は60%以下を目安に管理することで、再発リスクの低減につながります。
7-4. 改善後の再検査
除カビ・防カビ施工後は、再度菌数を測定し、改善の度合いを確認します。
数値で変化を追うことで、対策の効果を客観的に把握できます。
必要に応じて、追加対応の要否も判断しやすくなります。
8. まとめ|見えないカビ汚染は「空気」「付着」「水分」の3方向から把握する
今回の事例では、壁・天井は低含水率で、ベッドのスノコ裏面の付着菌数と家具木部の含水率が高いことが確認されました。
カビは見える部分を清掃しても、原因が残っていると再発することがあります。
空気中の菌数・付着菌数・含水率をあわせて確認することで、汚染の広がりや優先対応箇所を整理しやすくなります。
また、カビは体質によっては鼻炎や咳などの不調につながる可能性があるため、寮や福祉施設のように人が長時間過ごす空間では早めの把握と対策が重要です。
カビにお悩みの際は、ハーツリッチ株式会社(ハーツクリーン事業部)までご相談ください。
現地状況を確認のうえ、調査から改善提案、再発防止まで一貫してご案内いたします。

